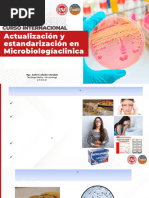

67% encontró este documento útil (3 votos)
4K vistas3 páginasReporte Interno Coprocultivo
Este documento resume el reporte de laboratorio de una paciente que presentó diarrea. El examen coproparasitario no mostró parásitos. Las pruebas bioquímicas identificaron Salmonella spp en las muestras. Se recomendaron antibióticos como clotrimoxazol y ciprofloxacina para el tratamiento.
Cargado por
Lizbeth VargasDerechos de autor
© © All Rights Reserved
Nos tomamos en serio los derechos de los contenidos. Si sospechas que se trata de tu contenido, reclámalo aquí.
Formatos disponibles
Descarga como DOCX, PDF, TXT o lee en línea desde Scribd
67% encontró este documento útil (3 votos)
4K vistas3 páginasReporte Interno Coprocultivo
Este documento resume el reporte de laboratorio de una paciente que presentó diarrea. El examen coproparasitario no mostró parásitos. Las pruebas bioquímicas identificaron Salmonella spp en las muestras. Se recomendaron antibióticos como clotrimoxazol y ciprofloxacina para el tratamiento.
Cargado por
Lizbeth VargasDerechos de autor
© © All Rights Reserved
Nos tomamos en serio los derechos de los contenidos. Si sospechas que se trata de tu contenido, reclámalo aquí.
Formatos disponibles
Descarga como DOCX, PDF, TXT o lee en línea desde Scribd